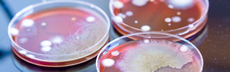
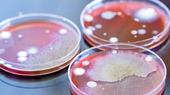

‘We can only break the poverty cycle through education’ For Rodney Naidoo, a teacher in the UNESCO Learning City of Durban, helping the most vulnerable students is more than a career, it’s a birthright.
Education is key
His grandfather had migrated from India to Durban in eastern South Africa’s KwaZulu-Natal province to earn money for his family by working in the sugarcane fields; he never finished high school.
Nevertheless, every month he would donate a part of his salary to the building of Natest Primary School– the school Naidoo is a teacher at today – to enable future young people to learn.
Change of plans
Rodney Naidoo
Building a democracy
Rodney Naidoo
Joining Natest Primary School
An estimated 80 per cent of the 600 students that attend Durban’s primary schools come from rural areas, most of them from disadvantaged homes, with less than 34 percent of parents paying school fees.
These challenges provide Naidoo and his colleagues with additional motivation to ensure that learners are equipped with the necessary tools, knowledge, skills and attitudes that will enable them to achieve their fullest potential and make a positive impact, both personally and within their communities.
Rodney Naidoo
Extra support before school hours
Naidoo wants to inspire his students to excel in maths in particular, which he sees as essential for success not only in South Africa but internationally.
Rodney Naidoo
Working with the families
Going the extra mile for his students
As part of a programme for disadvantaged students in Grade 12, Naidoo and further teachers used to travel to rural and remote areas during school holidays to provide learners with extra tuition before their final exams. They did this without remuneration until the programme was suspended when COVID-19 hit the country.
Until then, they had helped an estimated 800 learners in this way; additional volunteers having provided lunch for the students during this time. Feedback has shown that this additional help has had a positive effect on exam results.
Transforming lives through education
It is by harnessing this power that teachers around the world can improve the livelihoods of the world’s most vulnerable communities.
Rodney Naidoo
UNESCO Global Network of Learning Cities
The GNLC is an international policy-oriented network providing inspiration, know-how and best practice. The network’s mission is to support and accelerate the practice of lifelong learning in the world’s communities by promoting policy dialogue and peer learning among member cities, forging links, fostering partnerships, building capacities and developing instruments to encourage and recognize progress in building learning cities.
Learn more

‘We can only break the poverty cycle through education’
‘We can only break the poverty cycle through education’
 Education is key
Education is key
 Change of plans
Change of plans
 Rodney Naidoo
Rodney Naidoo
 Building a democracy
Building a democracy
 Rodney Naidoo
Rodney Naidoo
 Joining Natest Primary School
Joining Natest Primary School
 Rodney Naidoo
Rodney Naidoo
 Extra support before school hours
Extra support before school hours
 Rodney Naidoo
Rodney Naidoo
 Going the extra mile for his students
Going the extra mile for his students
 Transforming lives through education
Transforming lives through education
 Rodney Naidoo
Rodney Naidoo
 UNESCO Global Network of Learning Cities
UNESCO Global Network of Learning Cities